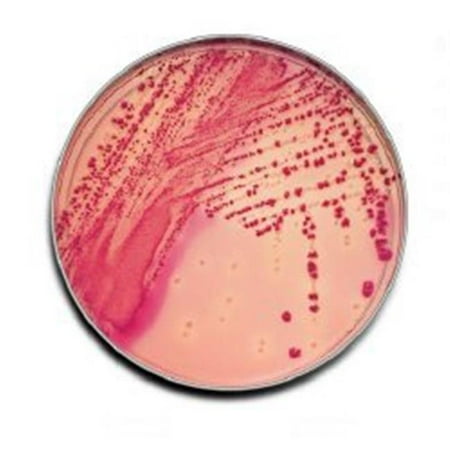

Last Updated: 2025-09-14 18:39:53
 Amazon
Amazon
 UnbeatableSale
UnbeatableSale
| Manufacturer | - |
|---|---|
| Brand | Doctor Dreadful |
| Item model number | DO2441995 |
| Color | Multicolor |
| Weight | - |
| Height | - |
| Depth | - |
| Product Id | 2963293 |
|---|---|
| User Reviews and Ratings |
3
(1 ratings)
3 out of 5 stars
|
| UPC | 753678453936 |
| # | Shop & Price | Reviews | User Ratings | Price |
|---|---|---|---|---|
| 1 |
Check on Amazon
Price:
Search
Visit
|
|||
| 2 |
12702400 Light Beige BBL Prepared Media - Pack of 100
Price:
$112.2
Visit
|
No reviews available yet.
Be the first to review this product!
Loading reviews...
Products you might like
Loading related products...